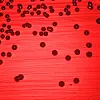

Anne Aamdal (t.v.) og Ingun Lund Witsø tester ut et nytt kjemisk fra UiO som skal hindre bakteriene i å samarbeideog danne biofilm. (Foto: Yngve Vogt)
Hindrer bakterier i å snakke sammen
Nytt kjemisk stoff fra UiO kan hindre bakterier i å snakke sammen. Da mister de evnen til å danne farlige bakteriebelegg i kroppen.
I samarbeid med forskningsmagasinet Apollon
Bakteriene har dessverre den enestående evnen at de kan sende advarselssignaler til hverandre når de blir utsatt for trusler, slik som antibiotikakurer. Signalene kan fanges opp av de andre bakteriene. Når konsentrasjonen av signalmolekyler har nådd et visst nivå, skjønner de andre bakteriene at det kan være fare på ferde. Da kan de unisont skru av og på visse gener for å beskytte seg.
Bakteriene sender ut mange ulike typer signalmolekyler. Noen er spesifikke. Noen er generelle. Forskere ved UiO har nå tatt et dypdykk i det vanligste signalmolekylet.
Molekylet, som har fått det lite sexy navnet AI-2 (Autoinducer-2), er et viktig signalmolekyl. Mange bakterier reagerer på AI-2 og bruker det til å kommunisere med hverandre.
– AI-2 er verdensspråket til bakteriene. Kall det gjerne bakterienes esperanto, forklarer professor Anne Aamdal Scheie på Institutt for oral biologi ved Universitetet i Oslo.
AI-2 regulerer og styrer mange brytere inne i bakterien og kan både sette i gang og endre uttrykket til en rekke gener. Molekylet sørger for at bakteriene blir flinkere til å overleve eller kolonisere seg.
– Dette handler blant annet om bakterienes evne til å bevege seg og til å feste seg på overflater. Biofilm. Når visse gener i bakterien skrus på, dannes en type proteiner på utsiden av celleveggen. Da er det lettere for bakterien å feste seg til en overflate. Når flere bakterier fester seg som et belegg på den samme overflaten, kalles det biofilm. Biofilm kan være et stort problem for pasienter med implantater. Det gjelder å sørge for at bakteriene ikke klarer å feste seg. Da har immunforsvaret større muligheter til å stoppe dem.
Vil lure bakteriene
– For å kunne fjerne bakterier i biofilm, må antibiotikakonsentrasjonen økes opptil hundre til tusen ganger. Det forklarer hvorfor det ikke er så lett å bli kvitt kroniske infeksjoner. Det er derfor veldig lurt å ta knekken på bakteriene før de rekker å feste seg.
Anne Aamdal Scheie og medarbeiderne hennes har de siste ti årene forsket på hvordan det er mulig å hindre bakteriene i å danne biofilm.
Målet deres har vært å lage et hemmende stoff, slik at bakteriene ikke klarer å motta signalmolekylene. Løsningen har vært å lage et kunstig molekyl som kan konkurrere med bakterienes egne signalmolekyler. Poenget er at de kunstige molekylene skal feste seg på de signalmottakerne der signalmolekylene selv skulle ha festet seg.
Det hemmende stoffet skal med andre ord begrense bakterienes muligheter til å skape infeksjoner. Hvis bakterien ikke hemmes, har den evnen til å dele seg og bli til flere bakterier. Hvis de blir mange nok, kan man bli syk.
– Vi vil lure bakteriene og tenker oss at vi skal gjøre dem stumme eller døve, slik at de verken klarer å sende eller høre signalene. Selv har vi jobbet med å gjøre bakteriene døve. Det vil si at de ikke lenger skal klare å ta imot signaler fra andre. En annen mulighet hadde vært å gjøre bakteriene stumme, det vil si å hindre at de produserer signaler, men det er en annen historie, forteller Ingun Lund Witsø, som nylig har avlagt doktorgraden sin om bakteriehemming på Institutt for oralbiologi ved UiO.
Stoffene lages på UiO
Forskerne har hentet sin inspirasjon fra algeforskning i sydlige farvann. I motsetning til andre sjøplanter blir ikke rødalgen Delisea Pulchra begrodd av bakterier. For å hindre tilgroingen, slipper algen ut noen spesielle, kjemiske stoffer som kalles furanoner. For en del år siden fant australske forskere den kjemiske strukturen til disse stoffene.
Professor Tore Benneche på Kjemisk institutt har syntetisert mange av furanonene. Det betyr at han har funnet en metode til å lage dem syntetisk på kjemilaben.
– Gjennom testing har vi kommet frem til at de syntetiske molekylene er enda mer effektive enn furanonene selv.
Tore Benneche har nå klart å lage vel 150 syntetiske varianter. De har fått det klingende navnet tiofenoner.
Molekylene er veldig små. Den eneste forskjellen er at det ene oksygenatomet i molekylet er byttet ut med et svovelatom.
Forsøkene viser at tiofenoner har en spesiell evne til å binde seg til de reseptorene der bakterienes egne signalstoffer selv skulle ha festet seg. Da vil ikke bakteriene få muligheten til å aktivere de sykdomsfremkallende genene sine, slik som når bakteriene blir angrepet med antibiotika.
– Metoden vår fører ikke til det samme selektive presset på bakteriene som antibiotika gjør. Da vil ikke bakteriene utvikle resistens på samme måte som når den blir utsatt for antibiotika. Forskjellen er at antibiotika prøver å drepe bakteriene. Det vil alltid være noen som overlever. Da får de resistensgener som kan deles med resten av populasjonen. Antikommunikasjonsmolekylene våre påvirker ikke bakterienes muligheter til å overleve. Derfor vil ikke bakteriene forsvare seg på samme måte. Noen hevder likevel at bakteriene kan utvikle resistens, men fordi stoffet vårt ikke fører til noe seleksjonspress, tror vi at risikoen for resistens er mindre og at det tar lengre tid, forteller Anne Aamdal Scheie.
Forskerne har nå testet ut alle de 150 variantene av tiofenonene.
– Noen fungerer ikke. Noen er giftige, mens åtte til ti av dem har vist seg å være veldig interessante. Konklusjonen vår er at tofenoner reduserer bakterienes evne til å feste seg til en overflate og danne biofilm – og til å uttrykke sykdomsfremkallende gener.
Bakteriebelegg på skip
Bakteriebelegg er et problem på alle fuktige steder der det finnes næring. I vannrør dannes det ofte biofilm. Biofilm fører til begroing. I oppdrettsnæringen må merder renses for begroing. Begroing er et spesielt stort problem på skip og oljeinstallasjoner og kan føre til korrosjon. Skip må legges i dokk for å fjerne begroing. I 2009 førte begroing og korrosjon til at Vallhall-feltet i Nordsjøen måtte stenges i ti uker.
– Vi ser for oss at stoffet vårt kan brukes av oljeindustrien, i mat- og fôrproduksjon og overalt der biofilm kan være et problem.
Sammen med Norsk institutt for vannforskning har UiO-forskerne testet ut flere typer tiofenoner for oljeindustrien.
– Det kan tenkes at vi må blande flere tiofenoner for å øke effekten. Vi tenker oss forskjellige
lengder på armene på molekylene og at hvert av molekylene har en lang arm som kan festes til ulike overflater. Det kan tenkes at effekten blir enda bedre om vi velger stoffer med forskjellige armlengder.
– Hvorfor er odontologer med på dette?
– Molekylene kan kanskje også brukes til å hindre biofilm på tenner og fyllingsmateriale i kroner og broer, for å unngå hull i tennene, tannkjøttbetennelse og tap av tenner, poengterer Anne Aamdal Scheie.
Denne artikkelen ble først publisert i forskningsmagasinet Apollon.